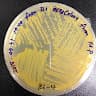

본 서비스에서 제공하는 사용자의 개인정보 데이터를 포함하여 각 정보주체의 동의 없이 데이터를 무단으로 수집하는 행위를 금지 및 거부합니다. 공개된 데이터도 크롤링 등 기술적 장치를 이용해 허가 없이 수집하는 경우 개인정보 보호법에 따라 형사처벌 될 수 있음을 알려드립니다.
© 2025 Rocketpunch, 주식회사 더블에이스, 홍원표, 대한민국 서울특별시 성동구 성수일로10길 12, 12층 1호, 04793, support@rocketpunch.com, +82 10-2710-7121
사업자등록번호 206-87-09615
더보기